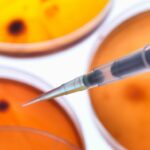

IQVIA Technologies hat sich mit dem White Paper “Generative AI: The Future of Pharmacovigilance” einem brandaktuellem Thema aus der Welt der Digitalisierung angenommen und mögliche Auswirkungen auf die Pharmakovigilanz diskutiert.
In der komplexen, sich schnell entwickelnden Pharmakovigilanz-Landschaft, in der die Datenmengen exponentiell wachsen, bietet generative künstliche Intelligenz (generative AI) das Potential, die Effizienz manueller Aufgaben zu verbessern und wertvolle Erkenntnisse aus den überwältigenden Datenmengen zu gewinnen. Generative AI steht jedoch noch am Anfang seiner Entwicklung, daher braucht es weiterhin den menschlichen Faktor, der die Kontrolle behält und die Aufsicht übernimmt.
Eine hochkarätig besetztes Panel an Experten hat im Rahmen einer Veranstaltung in Boston vor diesem Hintergrund eine Reihe von Fragen zur aktuellen Pharmakovigilanz-Landschaft, zu Herausforderungen und Chancen im Zusammenhang mit der Implementierung generativer KI in Pharmakovigilanz-Workflows und zu Strategien, die Life-Sciences-Unternehmen nutzen können, um eine reibungslose Integration generativer KI in diese Arbeitsabläufe zu erleichtern, diskutiert. Ihre Ein- und Ansichten wurden in das gegenständliche White Paper ausgearbeitet
Eine Landschaft im Wandel
Die Veränderungen in der Pharmakovigilanz-Landschaft wirken sich auf die Prioritätensetzung von Life-Science-Unternehmen aus. Dazu gehören zunehmende regulatorische Anforderungen, ein Mangel an qualifizierten Mitarbeitern und das Aufkommen von AI. Angesichts der Komplexität der heutigen Pharmakovigilanz-Landschaft haben Life-Sciences-Unternehmen ihren Einsatz digitaler Tools verstärkt und ziehen nun auch generative AI in Betracht. Viele innovative Anwendungen für generative AI in der Pharmakovigilanz zeichnen sich ab. Die Implementierung von generative AI als Teil von Pharmakovigilanz-Workflows bietet zwar Vorteile, birgt aber auch zahlreiche Herausforderungen, weshalb eine verantwortungsvolle KI-Implementierung für Sponsoren und Endnutzer unerlässlich ist.
Zukünftige Entwicklung von GenAI und Pharmakovigilanz gestalten
Abseits des Hypes um generative AI gibt es bereits praktikable Möglichkeiten, generative AI zu nutzen, um den Bereich der Pharmakovigilanz zu verbessern. Diese Möglichkeiten werden weiter und rasch wachsen. Generative AI hat das Potenzial, Zeit bei der Erstellung von IBs, Protokollen und Zulassungsanträgen zu sparen und gleichzeitig das Signalmanagement zu verbessern und zu beschleunigen.
Die Einführung und Umsetzung von generative AI ist jedoch mit Herausforderungen und Risiken verbunden, die es zu bewältigen gilt. Um einen Mehrwert zu bieten, muss generative AI für spezifische Anwendungsfälle eingesetzt werden, um konkrete Aufgaben zu lösen. Sie erfordert menschliche Aufsicht sowie eine kontinuierliche Validierung. Außerdem müssen Aspekte wie Datenschutz, Datenqualität, Integration und Kosten berücksichtigt werden.

Die Herausforderungen und Risiken sind zwar beträchtlich, aber es besteht die Zuversicht, dass diese Herausforderungen bewältigt und die Risiken beherrscht werden können. Es ist unrealistisch zu erwarten, dass generative AI perfekt ist, aber selbst wenn sie unvollkommen ist, kann sie immer noch eine erhebliche Verbesserung gegenüber dem aktuellen Stand darstellen und wird mit der Zeit einen größeren Wert bieten.
Das White Paper im englischen Original inklusive der Information zu den Autoren bzw. Panelisten steht Ihnen bei Interesse gerne unter folgendem Link kostenfrei zur Verfügung: Generative AI: The Future of Pharmacovigilance